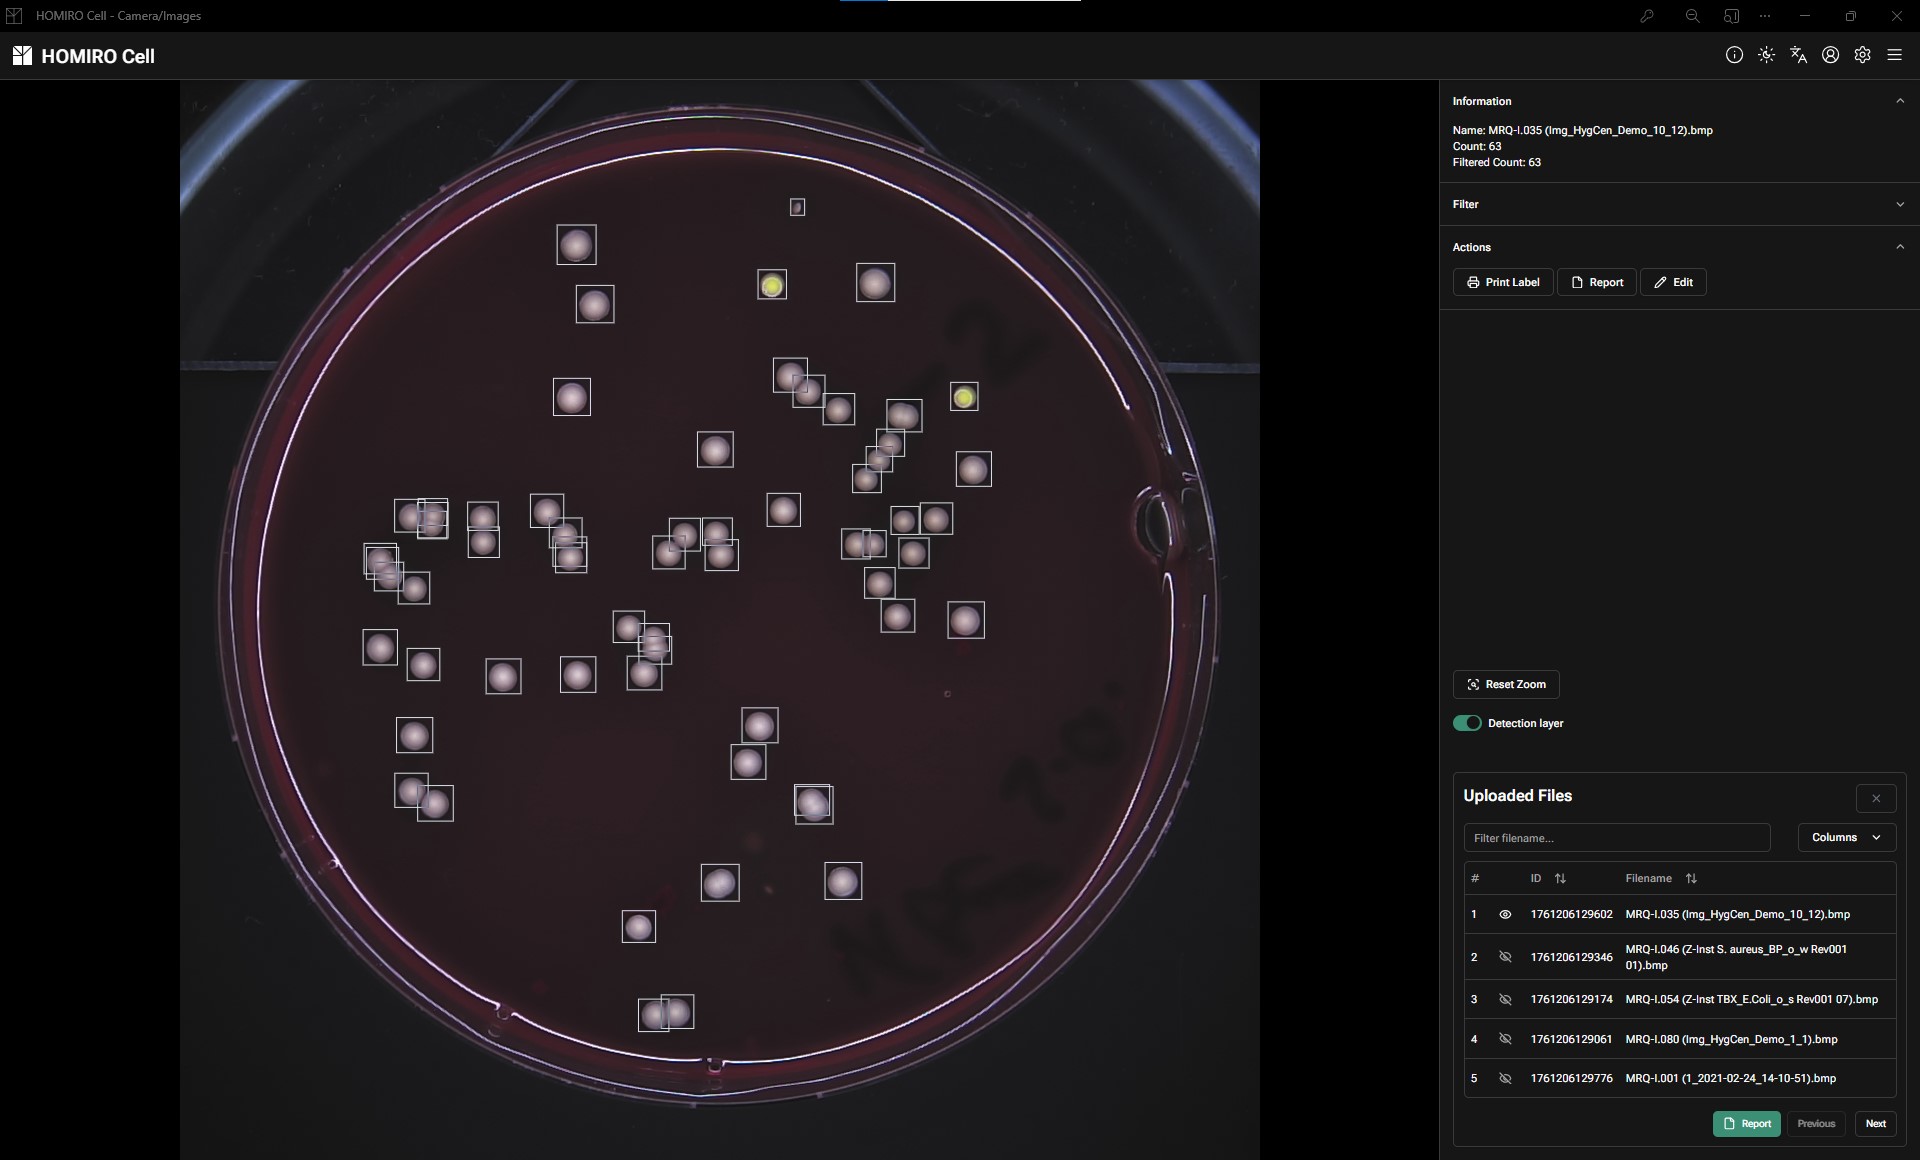
AI-assisted colony counting interface showing automated detection, filtering controls, and batch processing

The next generation of colony counting—
building it together with pilot customers.
Supervised AI workflow removes manual transcription errors and accelerates routine counts. On-prem optional, LIMS-ready, continuous improvements.
Target Industries
Food & Beverage
Quality control for food production and beverage manufacturing
Hygiene Products
Microbial testing for personal care and hygiene products
Water Testing
Environmental monitoring and water quality analysis
Cosmetics
Safety testing and quality assurance for cosmetic products
Pains → Gains
- Paper & Excel; manual re-typing
- Heavy configuration & review workload
- Variable images (lighting, distance, media)
- Slow & error-prone hand counts
- LIMS-inherent with signed PDF/JSON
- QC layer & profiles for repeatability
- Standardized capture (chamber, ring light, metadata)
- Reduced time per sample via supervised AI workflow
Manual vs AI-Assisted: Side-by-Side Comparison
See how AI-assisted workflow transforms your laboratory's colony counting process
| Metric | Manual Counting | AI-Assisted (Sentry Labs) |
|---|---|---|
| Time per Sample | 10-15 minutes Count + record + transcribe to LIMS | 2-3 minutes Insert → AI count → review → auto-sync |
| Accuracy | Variable (±10-20%) Depends on technician experience & fatigue | Target ±10% (validated) Consistent across samples & operators |
| Transcription Errors | 5-10% error rate Manual re-typing from paper/Excel to LIMS | Zero errors Direct digital transfer with barcode binding |
| LIMS Integration | Manual data entry Copy values from worksheets | Automatic sync API or CSV bridge with signed exports |
| Training Time | 2-4 weeks Learning accurate counting technique | 2-3 hours Understanding review workflow & QC checks |
| Audit Trail | Paper records or spreadsheets Manual signature tracking | Complete digital trail 21 CFR Part 11 ready, model versioning |
| Throughput per Hour | 4-6 samples Sequential processing only | 15-20 samples Parallel batch processing capability |
60-80% time reduction even with review workflow
See it in your lab — 30-day pilotVision & Current Status
- 60–80% time reduction per sample vs. manual counting
- ±10% accuracy across all standard media types
- Autonomous processing with confidence-scored results
- Zero transcription errors via direct LIMS integration
- Validated methods for regulatory compliance
- Continuous learning from customer deployments
We've completed a rigorous internal pilot study across diverse sample types— deliberately including challenging cases that competitor systems can't handle.
- Standard media (PCA, TBX, GVPC, YGC)
- Moderate colony density (20–500 CFU)
- Clear agar, distinct morphology
- Significant portion already meets ±15% accuracy target
- Very low counts (<10 CFU)
- Confluence/spreading colonies
- False positives (labels, bubbles, particles)
- Remaining samples require enhanced model training
- Near-term: Enhanced training on small objects, confluence patterns, and artifact filtering
- Mid-term: Confidence scoring system—auto-approve high-confidence counts, flag uncertain ones for review
- Long-term: Customer-specific model tuning and full IQ/OQ validation packages
We offer supervised deployment: Our AI counts, your technician reviews before finalizing. This gives you immediate time savings (even with review, it's faster than manual counting) while we refine accuracy on your specific sample types. As performance improves, the review burden decreases.
- 30-day trial with parallel processing (AI + manual validation)
- Fixed price, no long-term commitment required
- KPI report: Accuracy by sample type, time savings, error analysis
- Decision brief: Which sample types to deploy now vs. wait for improvements
What We're Building Toward
Current pilot phase: Significant portion of samples already meet production-ready thresholds; remaining samples under active improvement. See detailed status →
Process — 6 steps
Plate/Filter/Film
Barcode-linked
Automated count
QC layer
Export results
Next sample
See It In Action
Our intuitive interface guides you through each step, from AI-powered detection to export-ready results.
Validation & Risk Control
- Internal pilot study across diverse sample types including challenging cases
- Error source analysis: Major failure modes identified and categorized
- Performance benchmarking: Accuracy vs. manual count by sample type
- Outcome: Clear improvement roadmap + sample type suitability matrix
- KPIs: Time/sample, revision time, deviation to 2-rater manual
- Design: 3 media × 10 images × 3 colony loads with acceptance criteria
- Outputs: Validation report, SOP templates, training materials
- Timeline: Conducted during pilot deployment phase
- Signed PDF/JSON exports, complete audit trail
- User management with access rights hierarchy
- Integration via API/CSV-Bridge; barcode-binding per sample
- 21 CFR Part 11 readiness (electronic signatures, audit trails)
- On-premise/air-gapped deployment available
- Model versioning: Track which AI version counted each sample
- Drift monitoring: Alerts when model performance degrades
- Data sovereignty: Your images never leave your network (on-prem mode)
- Review your sample types vs. our suitability matrix
- Live demonstration on 3 media types
- Discuss integration requirements (LIMS, barcodes, workflow)
- Process 50-100 samples with parallel validation
- KPI measurement: accuracy, time savings, user acceptance
- Decision brief: Deploy now vs. wait for model improvements
Frequently Asked Questions
How accurate is AI-assisted colony counting?
Our system is currently in pilot phase with differentiated performance across sample types. In our internal pilot study (105 images, 22 sample types), approximately 50% of samples already meet production-ready accuracy thresholds of ±15% when compared to manual counting.
Production-ready now:Standard media (PCA, TBX, GVPC, YGC) with moderate colony density (20-500 CFU) and clear agar show the strongest performance.
Under improvement:Very low counts (<10 CFU), confluence/spreading colonies, and false positives from labels or bubbles require enhanced model training.
What's the difference between AI-assisted and fully automated?
AI-assisted (our current approach) means the AI detects and counts colonies, but a trained technician reviews and approves the count before it's finalized. This provides immediate time savings while maintaining quality assurance through human oversight.
Fully automated means the system counts without human review. We're working toward this with a confidence scoring system—high-confidence samples will auto-approve, while uncertain ones will flag for review.
Can it integrate with my existing LIMS?
Yes, through multiple methods:
- API Integration: Direct connection for real-time data transfer with barcode binding
- CSV Bridge: Export results as CSV files that your LIMS can import
- Signed Exports: All results include signed PDF and JSON with complete audit trails
We work with your IT team during the pilot phase to establish the integration method that fits your infrastructure.
What sample types are supported?
Currently supported:- Agar plates: PCA, TBX, GVPC, YGC, and other standard media
- Membrane filters
- Petrifilm (selected types)
- Colony density: 20-500 CFU (optimal range)
- Drop plates, OPKA, additional Petrifilm variants, inhibition zone analysis, air filter systems
How long does validation take?
We recommend a 30-day pilot program with parallel processing: process 50-100 of your real samples while running AI counts alongside your standard manual counts.
You'll receive:- KPI report showing performance by sample type
- Time savings and accuracy measurements
- Decision brief on which samples to deploy now vs. wait for improvements
IQ/OQ validation (for regulated environments) is conducted after the pilot phase when you're ready to formalize deployment.
Can the system be deployed on-premise or air-gapped?
Yes. We support multiple deployment models:
- On-premise: Full system installed within your facility—data never leaves your network
- Air-gapped: Complete isolation from internet connectivity—all processing local
- Cloud-assisted: Optional connectivity for model updates and monitoring
The system includes complete audit trails (21 CFR Part 11 ready), user access controls, and model version tracking regardless of deployment mode.
How much time does it actually save?
Target: 60-80% time reduction per sample compared to manual counting, even with the review step.
Typical manual workflow: 10-15 min/sampleRemove plate, transport, manual count (5-10 min), record in paper/spreadsheet, transcribe to LIMS, return plate
AI-assisted workflow: 2-3 min/sampleInsert plate (5 sec), AI counts (~10 sec), review (30-60 sec), one-click approve → auto-syncs to LIMS
Bonus: Zero transcription errors, reduced training time, parallel processing capability.
What training is required?
Initial training: 2-3 hours for laboratory staff covering sample insertion, understanding AI detection, review workflow, quality control checks, and LIMS integration usage.
Learning curve: Most technicians are comfortable after processing 10-20 samples.
Documentation provided:- SOP templates
- Video tutorials
- Quick reference guides
- In-app help system
Still have questions?
Schedule a 30-minute demo call